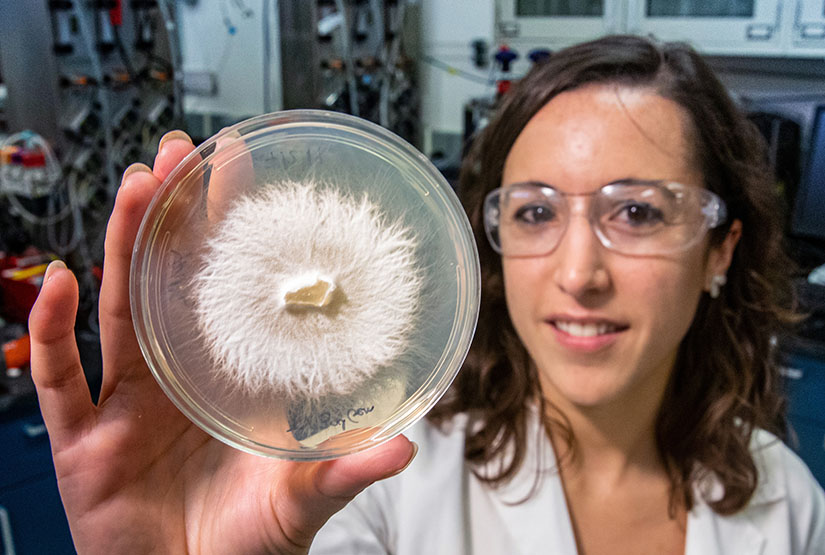
A researcher holds a petri dish containing white-rot fungi

News Release: Groundbreaking Research into White-Rot Fungi Proves Its Value in Carbon Sequestration from Lignin
A foundational study conducted by scientists at the National Renewable Energy Laboratory (NREL) shows for the first time that white-rot fungi are able to use carbon captured from lignin as a carbon source.
The research confirms a hypothesis from Davinia Salvachúa Rodriguez, the senior author of a newly published paper. Until now, scientists were unsure whether white-rot fungi—the most efficient lignin-degrading organisms in nature—actually consume the products generated from breaking down lignin.
“What we have demonstrated here is that white-rot fungi can actually utilize lignin-derived aromatic compounds as a carbon source, which means they can eat them and utilize them to grow,” Salvachúa said. “That is another strategy for carbon sequestration in nature and has not been reported before.”
The paper, “Intracellular pathways for lignin catabolism in white-rot fungi,” appears in the journal Proceedings of the National Academy of Sciences. Her co-authors from NREL are Carlos del Cerro, Erika Erickson, Tao Dong, Kelsey Ramirez, Venkataramanan Subramanian, Rui Katahira, Jeffrey Linger, Wei Xiong, and Michael Himmel. Other co-authors are from the Environmental Molecular Sciences Laboratory at Pacific Northwest National Laboratory and the Joint Genome Institute at Lawrence Berkeley National Laboratory.
Salvachúa, a research scientist in NREL's Renewable Resources and Enabling Sciences Center, has spent more than a decade studying white-rot fungi. Last year, the Department of Energy’s Office of Science awarded her a prestigious $2.5 million grant as part of the Early Career Research Program to further her work.
White-rot fungi evolved to degrade lignin, which Salvachúa calls “the most recalcitrant biopolymer on Earth.” Lignin helps make the plant’s cell walls more rigid. Other parts of the plant, such as cellulose, are also recalcitrant but can be fully depolymerized to single monomeric species for use as a biofuel and biochemical precursors, for example. But the intractability of lignin and the lack of an efficient method to deconstruct and convert lignin to monomeric compounds hampers the viability of plant-based biorefineries.
Salvachúa’s work forms the foundation of a new research area based on lignin being broken down by white-rot fungi, which could be further exploited to simultaneously convert the biopolymer into value-added compounds.
The researchers examined two species of white-rot fungi: Trametes versicolor and Gelatoporia subvermispora. Through the use of genomic analysis, isotopic labeling, and systems biology approaches, the researchers determined the ability of these organisms to incorporate carbon from lignin-derived aromatic compounds into central metabolism and were able to map out the potential aromatic catabolic pathways for that conversion process. Further, in vitro enzyme analyses enable validation of some of the proposed steps. The researchers also highlight that this work is just the beginning of a broad area towards discovering new enzymes and pathways and better understanding carbon flux in these organisms.
Lignin accounts for about 30% of the organic carbon in the biosphere. Concerns about the changing climate have sparked a growing interest in the issue of carbon cycling, in which carbon is absorbed by natural reservoirs—such as plants—from the atmosphere and later decomposed and returned to the atmosphere or other natural reservoirs. Because more carbon is stored in the soil than in the atmosphere or plants, white-rot fungi are now positioned as key players in the sequestration of lignin-derived carbon in soils.
Scientists have demonstrated the ability of some bacterial strains to break down lignin as well, but not as effectively as white-rot fungi. Salvachúa said bacteria are easier to work with than fungi because they grow more quickly, and many are genetically tractable, contrary to white-rot fungi. “With fungi, one experiment can be up to two months,” she said. “We try to be very careful when we plan an experiment because that’s a long time. That’s six experiments a year if you need results to move forward. With bacteria, you can do one per week.”
The Department of Energy’s Office of Science, Biological and Environmental Research program, funded a portion of the research, with other funding coming from the Laboratory Directed Research and Development program at NREL.
NREL is the U.S. Department of Energy's primary national laboratory for renewable energy and energy efficiency research and development. NREL is operated for the Energy Department by the Alliance for Sustainable Energy, LLC.
Last Updated April 28, 2026
